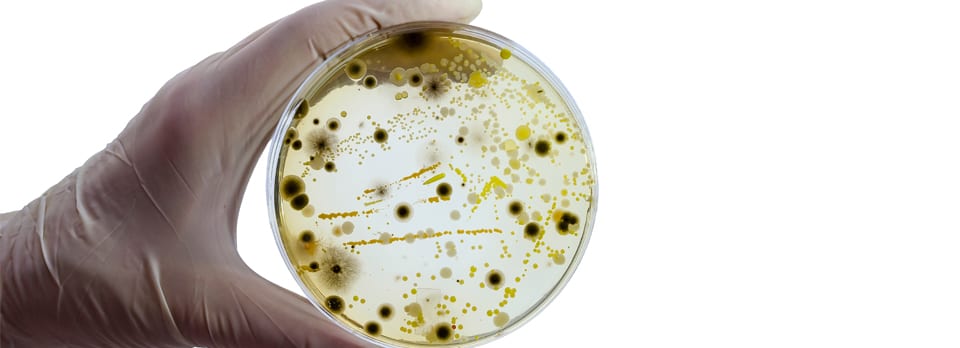
Psychobiome – Research for Brain Targeted Medications

Psychobiome – Emerging research is riding the wave of the ever-expanding world of the microbiome. This time, it's with the direct relationship that our microbes have with our brain. A very young start-up company called ‘Holobiome’ is currently in their 5th year of existence, however, has access to the largest collection of human gut microbes, and they intend on flipping the future of neuroscience on its head.
What they plan to learn from these microbes is absolutely fascinating! Everything from anxiety, depression, Alzheimer’s, and more!
What is ‘Psychobiome’?
The ‘Pyschobiome’ is likely not something you have heard of before, that’s because it’s a term coined by neuropharmacologist, John Cryan and psychiatrist Ted Dinan who are on the cusp of developing the first of its kind type of medicine - ‘Pyschobiotics’. A field of its own and in the very early years yet, but there are no delays, the data coming out on the microbiome is paving the way for a whole new era of medical literature and pharmacology[1].
This is a really young field as we mentioned, and when just a team of 8 are conducting the forefront of this research you can grasp just how young this is, relative to the medical data collated over centuries right up to what we have at this point.
Holobiome is looking to specialize in the fields of allergies, intestinal disorders, and even obesity. While other areas are keen to find the link between anxiety, depression, and neurological conditions via the vagal nerve/gut-brain axis. They have been warned by many not to speed forward with haste though, this is so young on the scale of innovation and that getting a ‘goldrush’ mentality might be detrimental to the foundation[1].
The Gut-Brain Axis
We have covered so much on the blogs and the podcasts on the gut-brain axis. In our most recent article Microbiome – 5 Things you didn’t know about your gut and one of our earlier articles – The vagus nerve. We really delved into the features of the microbiome and the gut-brain axis highway that is the vagus nerve and how even the temperature of what we drink instantly sets us up for digestion or adds a cold splash to the fire.
Our microbiome weighs in at more than our own brain for the perspective of insight, weighing in at on average 2kg in total, comparatively our brain weighs on average 1.4kg! With more genes to that of 1000 times our own, cashing in at 20 million unique genes in there and thousands upon thousands of species… it’s no wonder this unexplored universe is attracting the charter of scientists now. The theory is as old as time but the science is new – for instance, the greeks initially actually believed that mental disorders originated from the gut from too much black bile as part of the Hippocratic era, but he also believed in the balance of the four main liquids – Blood, black bile, phlegm, and yellow bile[3].
Our communication highway runs constantly up and down like traffic between our gut and brain influencing hormones, immune system, stress triggers, and is a key component of our entire nervous system.
Gut feeling on Mental Health
Researchers are particularly interested in the connection between the links like that of irritable bowel syndrome and depression[5,6] as a corresponding pathology, as well as those who are frequent users of antibiotics and depression vs those who use just antifungal and antiviral that leave the microbes untouched. Such connections are also being drawn that those on the spectrum may also have chronic digestive issues [7] and those with Parkinson’s also seem to have recurring constipation[8].
In 2019 – one of the largest studies was conducted on Belgian and Dutch origin people around microbial population correlation with depression. The first and largest human study done on the gut microbiome and its involvement with behavior and depression respectively. The research was conducted by the catholic university of Leuven in Belgium and led by Dr. Sara Vieria-Sila and Dr. Jaroen Raes. The study consisted of 1054 Belgians and 1063 individuals from the Netherlands, using 16S ribosomal ribonucleic acid gene sequencing (rRNA) to analyze fecal microbiota[9].
From their findings across the cohort studied – there were 2 deficient strains that appeared in the individuals presenting with depression. Dialister and Coprococcus genera were both deficient. Furthermore, they discovered specific neuroactive compounds that may better explain the relationship between gut microbes and our own quality of life, an example of this is seen with our metabolism pathways of GABA a powerful neurotransmitter responsible for the balance of excitation in the nervous system, and Tryptophan – both expressed n human gut microorganisms[9].
The Morse Code of Microbes
Advancements in this field of the 'psychobiome' are now seeing the potential to interpret secreted messenger signals from these microbes that may influence the rest of the body through both our blood and brain. There may also be signaling that is directed to other organs via communication from microbes to the vagus nerve, which as we have learned, is known as the wandering nerve. They believe that this communication comes from the recently discovered ‘neuropods’ that sit in the lining of our gut wall (see below).Enteroendocrine cells are sensory cells in the gut that communicate by releasing hormones locally through their own sufficient paracrine system, however, its recently been discovered that they also possess the ability to extend communication to distant cells including that of our nerves[10].

ref: https://www.sciencedirect.com/science/article/pii/S2352345X19300074
The next step for this morse code deciphering of the microbes will be on the frontier of inflammation research, the direct and indirect links with mental implications, and how those pathways are communicated in the body.
Psychobiome - A better understanding of the future of modern science
It is likely that from an abstract view there is a universe inside of us that we are yet to discover as we are a universe understanding itself at the very fundamentals of our material makeup. It’s hard to comprehend to just what level this will unfold and what it will evolve into going forward, but there is a race to the ‘Ah-ha’ discovery pinnacle. We just hope that ample time is taken to not rush to conclusions and we can embark in the depths of this whole new world to its full potential one day.In one recent article from 2019 – Psychobiome - feeding the mind, it was refreshing to see science reflecting on one particular element of nature that was being heavily studied; polyphenols. The interaction between these compounds found in our diet and the gut-brain axis[11]. We recommend checking this one out for some light but insightful reading. Here’s to the future!
References
1. Meet the psychobiome BY ELIZABETH PENNISI SCIENCE08 MAY 2020 : 570-573 Mounting evidence that gut bacteria influence the nervous system inspires efforts to mine the microbiome for brain drugs.
2. Ursell, L. K., Metcalf, J. L., Parfrey, L. W., & Knight, R. (2012). Defining the human microbiome. Nutrition reviews, 70 Suppl 1(Suppl 1), S38–S44. https://doi.org/10.1111/j.1753-4887.2012.00493.x
3. Kleisiaris, C. F., Sfakianakis, C., & Papathanasiou, I. V. (2014). Health care practices in ancient Greece: The Hippocratic ideal. Journal of medical ethics and history of medicine, 7, 6.
4. Matarazzo I, Toniato E, Robuffo I. Psychobiome Feeding Mind: Polyphenolics in Depression and Anxiety. Curr Top Med Chem. 2018;18(24):2108-2115. doi: 10.2174/1568026619666181210151348. PMID: 30526463.
5. Rosenblat, Joshua & McIntyre, Roger. (2017). Efficacy and Tolerability of Minocycline for Depression: A Systematic Review and Meta-Analysis of Clinical Trials. Journal of Affective Disorders. 227. 10.1016/j.jad.2017.10.042.
6. A review of antibiotics, depression, and the gut microbiome Wen-Zhi Hao InvestigationData curationWriting- Original draft preparation , Xiao-Juan Li Data curationWriting- Original draft preparation , Pei-Wen Zhang InvestigationData curation , Jia-Xu Chen Writing- Reviewing and Editing. https://doi.org/10.1016/j.psychres.2019.112691
7. Penzol, M. J., Salazar de Pablo, G., Llorente, C., Moreno, C., Hernández, P., Dorado, M. L., & Parellada, M. (2019). Functional Gastrointestinal Disease in Autism Spectrum Disorder: A Retrospective Descriptive Study in a Clinical Sample. Frontiers in psychiatry, 10, 179. https://doi.org/10.3389/fpsyt.2019.00179
8. Yu, Q. J., Yu, S. Y., Zuo, L. J., Lian, T. H., Hu, Y., Wang, R. D., Piao, Y. S., Guo, P., Liu, L., Jin, Z., Li, L. X., Chan, P., Chen, S. D., Wang, X. M., & Zhang, W. (2018). Parkinson disease with constipation: clinical features and relevant factors. Scientific reports, 8(1), 567. https://doi.org/10.1038/s41598-017-16790-8
9. Valles-Colomer M, Falony G, Darzi Y, et al. The neuroactive potential of the human gut microbiota in quality of life and depression. Nat Microbiol. 2019. doi: 10.1038/s41564-018-0337-x.
10. Liddle RA. Neuropods. Cell Mol Gastroenterol Hepatol. 2019;7(4):739-747. doi: 10.1016/j.jcmgh.2019.01.006. Epub 2019 Jan 30. PMID: 30710726; PMCID: PMC6463090.
11. Matarazzo I, Toniato E, Robuffo I. Psychobiome Feeding Mind: Polyphenolics in Depression and Anxiety. Curr Top Med Chem. 2018;18(24):2108-2115. doi: 10.2174/1568026619666181210151348. PMID: 30526463.